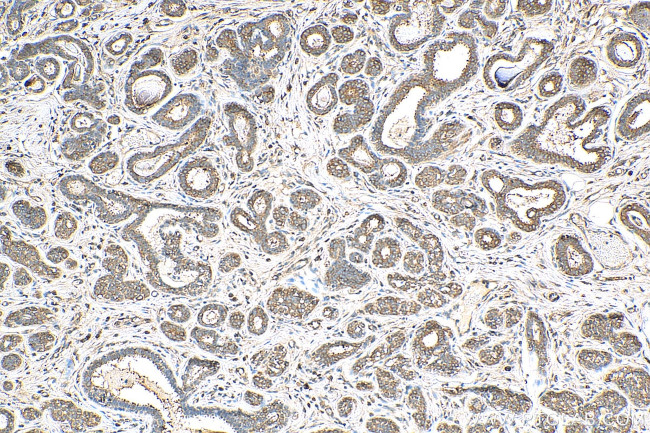
EEA1 Antibody in Immunohistochemistry (Paraffin) (IHC (P))

Search
Proteintech
EEA1 Polyclonal Antibody
{{$productOrderCtrl.translations['antibody.pdp.commerceCard.promotion.promotions']}}
{{$productOrderCtrl.translations['antibody.pdp.commerceCard.promotion.viewpromo']}}
{{$productOrderCtrl.translations['antibody.pdp.commerceCard.promotion.promocode']}}: {{promo.promoCode}} {{promo.promoTitle}} {{promo.promoDescription}}. {{$productOrderCtrl.translations['antibody.pdp.commerceCard.promotion.learnmore']}}
产品信息
28347-1-AP
种属反应
宿主/亚型
分类
类型
抗原
偶联物
形式
浓度
规格
纯化类型
保存液
内含物
保存条件
运输条件
产品详细信息
Aliquoting is unnecessary for -20°C storage.
靶标信息
Early endosomal antigen 1 (EEA1) is a 162 kDa membrane bound protein component specific to the early endosome and is essential for fusion between early endocytic vesicles. Early endosomes are cytoplasmic compartments which fuse with endocytic vesicles for redistribution of extracellular compounds to alternate destinations. Zinc-finger-like domains, reminiscent of those found in nucleic acid binding proteins, are located in the amino and carboxyl-terminal domains of EEA1. The carboxyl-terminal zinc-finger-like-domain is conserved in several other non-nuclear proteins, some of which are also involved in intracellular protein trafficking. In addition, this domain is an authentic zinc-binding domain and is critical to the intracellular localization of EEA1. Membrane association of EEA1 has been shown dependent on phosphatidyl 3-kinase activity, inhibitors of which cause EEA1 to dissociate from early endosomes.
仅用于科研。不用于诊断过程。未经明确授权不得转售。
生物信息学
蛋白别名: Early endosome antigen 1; early endosome antigen 1, 162kD; early endosome-associated protein; Endosome-associated protein p162; unnamed protein product; Zinc finger FYVE domain-containing protein 2
基因别名: A430109M19Rik; B230358H09Rik; EEA1; MST105; MSTP105; ZFYVE2
UniProt ID: (Human) Q15075, (Mouse) Q8BL66
Entrez Gene ID: (Human) 8411, (Rat) 314764, (Mouse) 216238